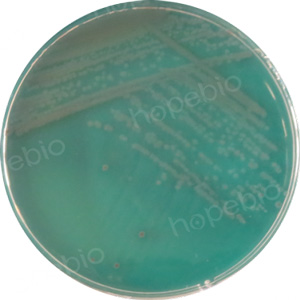

海博微信公众号
海博微信公众号
 海博天猫旗舰店
海博天猫旗舰店


 海博微信公众号
海博微信公众号
 海博天猫旗舰店
海博天猫旗舰店




一、弧菌属
1.弧菌介绍
弧菌属于变形菌门、γ-变形菌纲、弧菌目、弧菌科。该属细菌最显著的特征是氧化酶阳性(少数例外)和需要钠离子(Na+)刺激生长,这也是其在培养基中常需要添加氯化钠的原因。
弧菌为不产孢子的短杆菌,轴弯曲或直,0.6×(1.5~3.0)μm,单个或偶尔联成S形或螺旋形。以单极生鞭毛运动,或有些种在细胞一端丛生两根或更多根鞭毛。很少不运动。常见于淡水或海水中,可因食用未充分加热或生的水产品或暴露在污染源的食物,引起肠胃炎、腹泻、发烧等。
弧菌中常见对人类存在致病作用的有12种,包括副溶血性弧菌、创伤弧菌、霍乱弧菌、溶藻弧菌、拟态弧菌、霍利斯性菌、弗尼斯弧菌、梅氏弧菌、美人鱼弧菌、辛辛那提弧菌、鲨鱼弧菌。
2.主要致病性弧菌的特性介绍
弧菌为革兰氏阴性,除梅氏弧菌外均为氧化酶阳性,不抗酸,为兼性厌氧菌,无严格的营养要求,通常见于淡水或海水中。除霍乱弧菌和拟态弧菌之外均为嗜盐性,营养琼脂中添加NaCl后也可促进霍乱弧菌和拟态弧菌的生长。
副溶血性弧菌(V.parahaemolyticus),为革兰氏阴性多形态杆菌或弯曲弧菌,无荚膜,无芽孢,有极生鞭毛,具有嗜盐性,最适氯化钠浓度为35 g/L,最适温度为37℃,最适pH为7.7~8.0,但pH9.5时仍能生长。在氯化钠胰蛋白胨大豆琼脂平板上,菌落呈圆形、微凸、光滑湿润、无色、半透明、边缘整齐,直径约2 mm~3 mm。致病性较强的菌株在含高盐甘露醇的兔血和人О型血的琼脂平板上产生β溶血(神奈川现象)。
创伤弧菌(V.vulnificus),为革兰氏阴性,显微镜下菌体为棒状、弧状、卵圆状等多种形态,无芽孢。在氯化钠胰蛋白胨大豆琼脂平板上,菌落呈圆形,乳白色,湿润,凸起,表面光滑,直径1 mm~2 mm。
霍乱弧菌(V.cholerae),为革兰氏阴性,呈弧形或逗点状,无芽孢,有菌毛,有些菌株有荚膜,一端有一根单鞭毛,运动活泼。可在pH6.8-10.2范围内生长。在碱性平板上,菌落呈圆形,光滑,透明直径约2 mm。
二、弧菌的常用鉴别或选择性培养基
1.常见弧菌在鉴别或选择性培养基上的菌落形态
(1)硫代硫酸钠-柠檬酸钠-胆盐-蔗糖(TCBS)琼脂
本产品用于食品微生物检验中致病性弧菌的选择性分离
弧菌接种TCBS琼脂,经过36℃培养18 h-24 h后,副溶血性弧菌不利用蔗糖,可将其与其他发酵蔗糖的弧菌进行区分。
|
|
|
|
副溶血性弧菌ATCC 17802 圆形,蓝绿色,斗笠状菌落 |
霍乱弧菌非O1群 圆形,黄色,扁平状菌落 |
图1 弧菌在TCBS琼脂平板上的生长特征
(2)弧菌显色培养基(第二代)
弧菌显色培养基(第二代)是青岛海博生物公司改良的培养基,用于食品、海产品、病人粪便样品和水产品中副溶血性弧菌的快速检测。
弧菌接种培养基,经过36℃培养18 h-24 h后,副溶血性弧菌呈蓝绿色且菌落比较大;创伤弧菌和霍乱弧菌显紫红色,溶藻弧菌显淡黄色或米黄色;其它细菌绝大部分被抑制。
|
|
|
|
副溶血性弧菌ATCC 17802 圆形,蓝绿色,较大菌落 |
创伤弧菌ATCC 27562 圆形,紫红色菌落 |
|
|
|
|
霍乱弧菌非O1群 圆形,紫红色菌落 |
溶藻弧菌ATCC 17749 圆形,淡黄色或米黄色菌落 |
图2 弧菌在弧菌显色平板上的生长特征
(3)庆大霉素琼脂培养基
培养基用于霍乱弧菌的分离培养。
弧菌接种培养基,经过36℃培养14 h-18 h后,霍乱弧菌在生长过程中可将亚碲酸钾的碲离子(Te4+)还原为金属碲(Te0),从而在菌落中心形成灰黑色或灰褐色沉淀,菌落呈圆形、扁平湿润、黑色中心。

霍乱弧菌非O1群
圆形,扁平湿润,黑色中心菌落
图3 霍乱弧菌在庆大霉素琼脂平板上的生长特征
(4)四号琼脂培养基
培养基用于霍乱弧菌的选择性分离。
弧菌接种培养基,经过36℃培养14 h-18 h后,霍乱弧菌在生长过程中可将亚碲酸钾的碲离子(Te4+)还原为金属碲(Te0),从而在菌落中心形成黑色沉淀,菌落呈圆形、扁平湿润、黑色中心。
霍乱弧菌非O1群
圆形,扁平湿润,黑色中菌落
图4 霍乱弧菌在四号琼脂平板上的生长特征
(5)改良纤维二糖多粘菌素B多粘菌素E(mCPC)琼脂培养基
培养基用于致病性弧菌的选择性分离。
弧菌接种培养基,经过36℃培养18 h-24 h后,创伤弧菌发酵纤维二糖,呈圆形、扁平,光照下呈透明或中心不透明但边缘透明的黄色至橘黄色菌落,菌落周围可出现(或不出现)黄色晕圈。
|
|
|
|
创伤弧菌ATCC 27562 圆形,边缘透明,黄色菌落 |
霍乱弧菌非O1群 圆形,紫色菌落 |
图5 弧菌在mCPC平板上的生长特征
2.菌落特征对照表
为方便快速对照各常见弧菌的菌落形态及特征,制作下表以便查阅。
表1菌落特征对照表
|
培养基名称 |
弧菌种类 |
|||
|
霍乱弧菌 |
副溶血性弧菌 |
创伤弧菌 |
溶藻弧菌 |
|
|
TCBS琼脂 |
圆形、半透明、表面光滑的黄色菌落 |
圆形、半透明、表面光滑的蓝绿色斗笠状菌落 |
圆形、半透明、表面光滑的绿色菌落 |
圆形,黄色,扁平状菌落 |
|
弧菌显色(二代) |
圆形,紫红色菌落 |
圆形,蓝绿色,较大菌落 |
圆形,紫红色菌落 |
圆形,淡黄色或米黄色菌 |
|
庆大霉素琼脂 |
圆形,扁平湿润,黑色中心菌落 |
淡黄色菌落,菌落偏小 |
-- |
-- |
|
四号琼脂 |
圆形、扁平湿润、黑色中心菌落 |
淡黄色菌落,菌落偏小 |
-- |
-- |
|
mCPC琼脂 |
圆型、紫色菌落 |
-- |
圆形,边缘透明,黄色菌落 |
-- |
三、相关培养基的采购
九州登录网页中国有限公司有适用于弧菌鉴定和选择性分离的相关培养基,客户可根据实际情况和用途进行选用。
|
产品编号 |
产品名称 |
规格 |
产品说明及用途 |
|
HB8631 |
250g |
用于副溶血性弧菌的纯化培养和血清学试验时增菌培养 |
|
|
HB4135 |
250g |
用于副溶血性弧菌神奈川现象试验 |
|
|
HB4130 |
250g |
用于致病性弧菌的选择性分离 |
|
|
HB7011-5 |
1000mL |
用于弧菌的显色培养 |
|
|
HB4133-2 |
250g |
用于霍乱弧菌的分离培养(GB标准) |
|
|
HB4134 |
250g |
用于霍乱弧菌的选择性分离培养 |
|
|
HB4151 |
250g |
用于致病性弧菌的选择性分离 |
注:本文属海博生物原创,未经允许不得转载。
上一篇:食品中的致病微生物
下一篇:没有了!
| 相关文章: | ||



